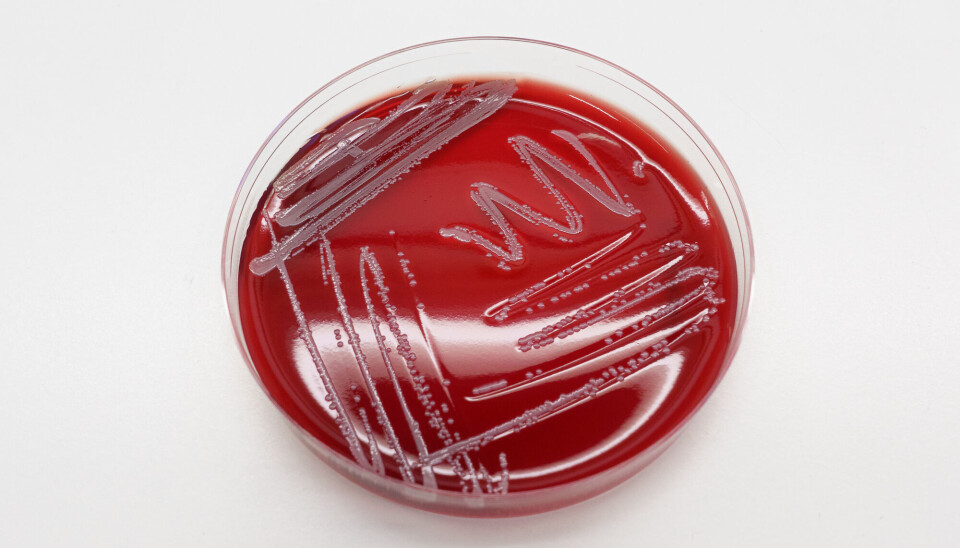

THIS CONTENT IS BROUGHT TO YOU BY UiT The Arctic University of Norway - read more
Newly identified bacterium named after the Northern Lights is resistant to antibiotics
Staphylococcus borealis has been found to be resistant to several different types of antibiotics, posing a potentially significant problem for the elderly.

In 2020, a research group at UiT The Arctic University of Norway discovered a previously unknown bacterium.
You may have heard of Staphylococcus aureus – or golden staph – but this one belongs to the white variety.
The newcomer, discovered in Northern Norway, was proudly named Staphylococcus borealis (S. borealis) after the Northern Lights.
But how dangerous is it really? And is it a threat to us at all?
33 per cent antibiotic resistance
To investigate this, researchers collected bacterial samples stored in freezers at several Norwegian hospitals.
The samples went as far back as 2014, and the researchers conducted new tests to see if they could identify the new bacterium in the old samples. Meanwhile, new samples arriving at the UiT lab from 2020 to 2024 were tested continuously.
In total, the researchers collected and analysed 129 samples from 7 Norwegian hospitals.
It turns out that S. borealis is resistant to more than three different classes of antibiotics in one-third of the cases where it was tested.
"We see the most resistance against the antibiotic classes fusidic acid, cephalosporins, penicillins, macrolides, and fluoroquinolones," says Jorunn Pauline Cavanagh, who led the work on bacterial analyses.
The bacterium also appears to be very good at picking up protective mechanisms from other bacteria. This means it could quickly become resistant to antibiotics when treated with the medicines currently available.
A problem for the elderly
S. borealis is a bacterium that lives on our skin, and researchers have found that it can become problematic when your immune system is weakened.
This makes it particularly concerning for the elderly and for those who have had knee or hip replacements.
"This bacterium is an opportunist that can cause illness when your immune system is compromised. For example, we see that it can form what’s called biofilm around knee prostheses and cause infections that can be difficult to treat," explains Cavanagh.
Researchers are now working to determine which diseases this bacterium can cause. Preliminary findings suggest it may lead to urinary tract infections, as well as inflammation in areas where implants are present.
"We do know that it causes mastitis in dromedary camels. This is because we’ve published the bacterium’s genetic profile in international databases, which other researchers use to compare their own bacterial findings. So, more possibilities may emerge," says Cavanagh.
Reference:
Cavanagh et al. Revealing the clinical relevance of Staphylococcus borealis, Microbiology Spectrum, vol. 13, 2025. DOI: 10.1128/spectrum.01988-24

This content is paid for and presented by UiT The Arctic University of Norway
This content is created by UiT's communication staff, who use this platform to communicate science and share results from research with the public. UiT The Arctic University of Norway is one of more than 80 owners of ScienceNorway.no. Read more here.
More content from UiT:
-
International women's day:Why AI performs worse for women
-
New study: Streptococcal vaccines are both safe and effective
-
Should you tailor your workouts to your menstrual cycle? Research suggests it may not be that straightforward
-
Diabetes medicine without needles? Researchers are now testing edible insulin
-
Marine heatwaves do not affect fish
-
Probiotics are beneficial for preterm babies